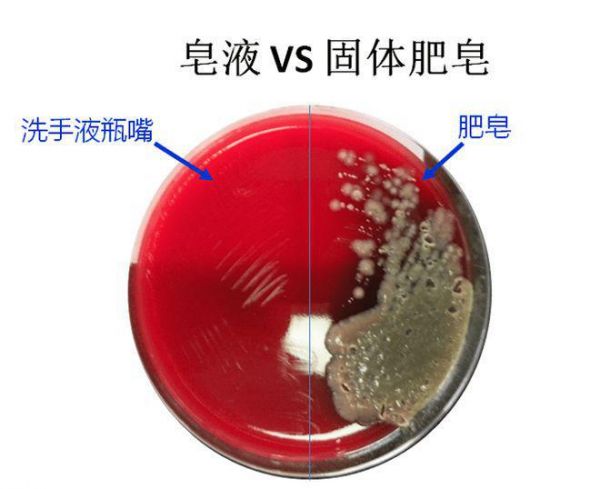

受访专家:北京大学人民医院感染管理-疾病预防控制处处长匡季秋、皮科副主任(主任医师)李厚敏、检验科副主任华文浩、儿科主治医师丁明明
供稿:北京大学人民医院宣传中心钟艳宇、感染管理-疾病预防控制处 郝云霄
看似简单的洗手动作,你真的做对了吗?
日常生活中,从餐前便后到接触公共物品,双手频繁接触外界环境,却往往成为病菌传播的“隐形桥梁”,而正确洗手能降低很多疾病传播风险。
正值初夏,气温攀升,一些传染病也进入高发期——诺如病毒、手足口病、肠道感染等均可能通过“脏手”入侵人体。如何让洗手真正成为健康的“防火墙”?
本文邀请北京大学人民医院感染管理-疾病预防控制处(以下简称感控处)、皮科、检验科和儿科专家,带您一起揭秘10个颠覆认知的手部健康真相。
1、这么多年都洗错了,标准洗手流程怎么做?
你知道吗?指尖和大拇指是手污染的重灾区,很多人洗手都漏掉了这个动作。正确洗手,要记住六步洗手法:内-外-夹-弓-大-立-完(腕),整个过程揉搓时间至少15秒。

研究显示,采用六步洗手法的手部细菌污染残留率比普通洗手低67%。
这些洗手误区,您要注意——
简单用清水冲一下,无法有效去除细菌和病毒。
洗手时间过短,揉搓过程不足15秒。
洗手不用洗手液或肥皂,仅用水清洗,
忽略指尖、指缝、拇指等部位。
共用擦手不及时清洗,导致擦手后二次污染。
专家提醒:流动水冲洗是最好的,盆接水洗手等于“细菌循环”,也就是洗干净又污染了。
2、如何科学选择家用洗手液?
洗手液抑菌率99%?不要被市场宣传误导。家用洗手液的主要成分是表面活性剂,部分产品含有抗菌、抑菌成分,洗手的过程主要是清洁去污作用,不必过分追求抗菌或抑菌作用。选择洗手液应关注其执行标准为国家或地方标准、保质期在有效期内,选择正规厂家生产的产品。
3、显微镜下洗手液是如何消灭病菌的?
例如,将含有对氯间二甲苯酚(PCMX,一种低毒抗菌剂)的洗手液滴入大肠杆菌样本,通过4K显微镜可以看到:(PCMX可以穿透细菌细胞膜脂质双层,导致细胞膜结构崩解,内容物(如离子、酶、ATP等)外泄,细胞失去渗透压平衡而死亡。
含75%浓度酒精的免洗手消毒液,对革兰阳性球菌(金葡菌)效果更好。
4、不爱洗手,会发生什么?
研究显示,接触污染物后不洗手,污染的手部会藏匿大量的病原体,包括大肠杆菌、金黄色葡萄球菌致病菌和各种病毒。俗话说“病从口入”,污染的手接触口鼻增加呼吸道、消化道疾病的感染率,儿童更容易出现肠道寄生虫。
专家建议:饭前、便后、处理食物前、外出回家后,处理垃圾后、接触公共物品后(如电梯按钮、电梯扶手等),用手遮挡打喷嚏、咳嗽或擤鼻涕后,照顾病人后等等,用流动水+肥皂/洗手液正确洗手,可以最大限度减少疾病传播风险。
5、洗手液和肥皂,哪个洗手效果更好?
www.share.hanflux.com
read.share.hanflux.com
3g.hanflux.com
indvschna.hanflux.com
world.hanflux.com
qualification.hanflux.com
wap.hanflux.com
www.wap.hanflux.com
list.hanflux.com
laliga.hanflux.com
www.share.zhouvora.com
read.share.zhouvora.com
3g.zhouvora.com
indvschna.zhouvora.com
world.zhouvora.com
qualification.zhouvora.com
wap.zhouvora.com
www.wap.zhouvora.com
list.zhouvora.com
laliga.zhouvora.com
www.share.xiancrypt.com
read.share.xiancrypt.com
3g.xiancrypt.com
indvschna.xiancrypt.com
world.xiancrypt.com
qualification.xiancrypt.com
wap.xiancrypt.com
www.wap.xiancrypt.com
list.xiancrypt.com
laliga.xiancrypt.com
www.share.yunzoro.com
read.share.yunzoro.com
3g.yunzoro.com
indvschna.yunzoro.com
world.yunzoro.com
qualification.yunzoro.com
wap.yunzoro.com
www.wap.yunzoro.com
list.yunzoro.com
laliga.yunzoro.com
www.share.beiwex.com
read.share.beiwex.com
3g.beiwex.com
indvschna.beiwex.com
world.beiwex.com
qualification.beiwex.com
wap.beiwex.com
www.wap.beiwex.com
list.beiwex.com
laliga.beiwex.com
www.share.qixrion.com
read.share.qixrion.com
3g.qixrion.com
indvschna.qixrion.com
world.qixrion.com
qualification.qixrion.com
wap.qixrion.com
www.wap.qixrion.com
list.qixrion.com
laliga.qixrion.com
www.share.duanchip.com
read.share.duanchip.com
3g.duanchip.com
indvschna.duanchip.com
world.duanchip.com
qualification.duanchip.com
wap.duanchip.com
www.wap.duanchip.com
list.duanchip.com
laliga.duanchip.com
www.share.meiflux.com
read.share.meiflux.com
3g.meiflux.com
indvschna.meiflux.com
world.meiflux.com
qualification.meiflux.com
wap.meiflux.com
www.wap.meiflux.com
洗手液主要通过表面活性剂和机械摩擦的作用来清洁手部。表面活性剂能够降低水的表面张力,帮助去除手上的油脂和污垢。此外,部分洗手液还含有抗菌成分,如三氯生、苯扎氯铵等,这些成分能够有效杀灭细菌和病毒。
肥皂的主要成分是脂肪酸和碱性化合物,具有较强的碱性及脱脂性,能够有效去除手上的油脂和污垢。肥皂在碱性条件下,会破坏细菌的细胞壁,从而达到除菌效果。肥皂在使用过程中可能会因潮湿而滋生细菌,造成二次污染和交叉感染的风险。
专家提示:在不能保证肥皂保持清洁干燥的情况下,建议使用洗手液和流动水洗手。
6、儿童户外玩耍,需要每次触摸地面都洗手吗?
不一定。应评估环境风险,按具体情况进行处理。
研究表明,过度清洁会破坏儿童免疫系统。儿童早期接触自然环境中的微生物(如泥土中的母牛分枝杆菌,可刺激Th1型免疫反应),反而能降低过敏风险。
有研究显示:农村儿童哮喘发病率比城市儿童低30%,与其接触土壤微生物有关。每天洗手超8次的孩子,湿疹风险反而增加25%。这可能与频繁使用抗菌产品,破坏了皮肤菌群平衡,导致了免疫耐受缺陷(免疫细胞敌我不分)有关。
专家建议:接触自然土壤、落叶等(无动物粪便/化学污染物);空地玩耍后手部仅有尘土,无明显污渍或伤口的,用清水冲洗即可,保留皮肤表面有益菌群。
而遇到这些情况,比如:触碰动物粪便、腐烂植物;手部有明显污渍、血迹或化学残留(如农药);进食前或触碰口鼻黏膜前;接触了生病小朋友的口鼻分泌物(鼻涕、唾液)后;手部有伤口……需要正确洗手。
7、手有小伤口时,如何正确洗手?
生活中难免小磕小碰,手部或四肢出现小的浅表伤口时,科学洗手需兼顾“清洁”与“防护”,避免感染风险。
可以通过“六步洗手法-流动水冲洗-伤口护理”三步法,有效去除病原体,具体做法如下:
六步洗手法:在流动水下充分淋湿双手,取适量洗手液或肥皂,均匀涂抹至整个手掌、手背、手指及指缝,冲洗双手时,如伤口在手部,避免污水倒流污染伤口。
流动水冲洗:先用流动清水冲洗伤口,去除表面污物,再使用洗手液或肥皂揉搓并用大量流动水冲洗,彻底清除污染。用一次性干净纸巾或无菌纱布轻轻按压吸干水分,避免用力擦拭。
伤口护理:用干净棉签蘸取碘伏消毒液,从中心向外围螺旋消毒伤口及周围皮肤,如伤口过大或过紧,建议到医院请专业人员处理。
专家提示:小伤口的关键在于用大量流动水或清洁剂冲洗伤口,去除污染,切忌不要用‘土方’撒香灰、牙膏等增加感染风险。
8、手经常起倒刺,该怎么护理?
手部倒刺(医学称“甲周逆剥”)是角质层干燥剥离所致。通常与皮肤屏障受损、营养缺乏、导致皮肤修复能力下降有关。
指甲周围皮肤缺乏皮脂腺,频繁接触水、清洁剂或物理摩擦(如美甲、做家务、儿童啃咬)会破坏角质层结构,导致干燥开裂;还有一些长期偏食者、糖尿病或免疫抑制的人群也容易出现。
倒刺不是缺维生素,专家强调,倒刺的护理需遵循“三步法”——保湿、修剪、防护,而非盲目补充维生素。即温水泡软后剪除,涂抹护手霜并按摩甲周,并在做家务时佩戴橡胶手套,避免直接接触洗洁精、消毒液;纠正咬指甲、撕倒刺等习惯。
专家提示:若倒刺周围出现红肿、疼痛,需修剪后涂抹碘伏消毒。若倒刺周围红肿超过1cm、伴脓性分泌物,需及时就医,避免延误病情。
9、如何养护出一双健康美丽的手?
手部健康需兼顾“清洁”与“养护”,二者缺一不可。
洗手,日常使用一些含有保湿成份的洗手产品和刺激性小的产品,尤其是对于过敏性皮肤。
除了洗干净手,还要注重手部养护,包括做家务戴橡胶手套;洗手后涂抹护手霜,手干明显者可以采用夜间厚敷凡士林,佩戴棉质手套过夜;做好防晒,避免紫外线导致色斑和老化;定期去角质、做手膜,促进新陈代谢;修剪指甲等。
只要遵循“科学洗手-深度保湿-防晒防护-定期护理”四步法,可有效减少手部问题,让您拥有一双健康且美丽的手。
专家提示:不要频繁用含酒精的免洗洗手液(速干手消毒液)过度清洁,高频洗手人群勤涂护手霜,当手部皮肤持续干燥、脱屑、红肿,需就医排查湿疹、银屑病等皮肤病问题。
10、湿纸巾能直接替代洗手?
不能完全替代。
我们知道,洗手是洗手液里的表面活性剂通过在指缝、指尖的物理摩擦后,利用流动水去除污垢和微生物的。
日常生活中用于手部的湿巾包括卫生湿巾和消毒湿巾两种,可以在外出洗手不方便时起到快速清洁手部卫生和部分杀菌的功能。
而依赖湿纸巾的擦拭动作和有限成分,仅能清除部分细菌,且无法彻底清除油脂和附着性污垢。且不同类别的湿纸巾(酒精类、非酒精类)添加的一些成分,长期使用可能破坏皮肤屏障,有引发接触性皮炎的风险。
所以,湿纸巾作为便携清洁的补充手段,在无水源时应急使用,正确洗手仍是预防疾病传播的“金标准”。
专家提示:消毒湿巾不适用于婴幼儿皮肤及婴幼儿用产品的消毒。
正确洗手,不仅是个人、家庭,更是全球健康的防线。从今天开始,用科学方法守护双手,让每一次清洁都成为阻断疾病传播的“隐形牌”。
相关知识
揭秘你不知道的洗发水真相
睡觉姿势大揭秘:哪种最健康
睡眠姿势大揭秘:哪种睡姿最健康
坐着时双腿并拢有益健康?专家揭秘真相
专家揭秘:最有益健康的6大性爱姿势
健康真相NO.406丨救命!这些 “舒适姿势” 竟是健康杀手!快自查你中招了吗?
减肥仪真能替代跑步?专家揭秘真相
手相生命线:揭秘你的健康与活力
这些年,你坐的姿势可能是错的
睡姿大揭秘:你睡对了吗
网址: 你洗手的姿势可能错了!专家揭秘10大手部健康真相 https://m.trfsz.com/newsview1334188.html